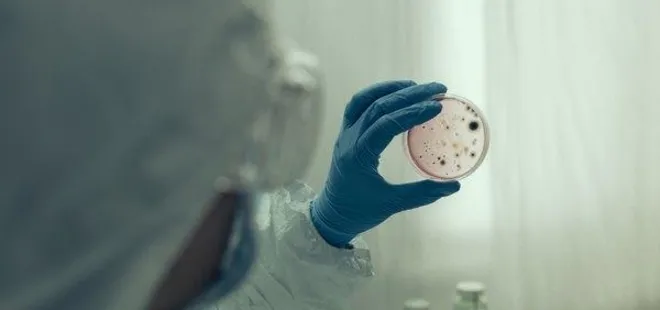

Yeni salgın alarmı! Kan kusuyorlar
Son dakika haberine göre; Çin'in Wuhan kentinde ortaya çıkan ve tüm dünyada her geçen gün can almaya devam eden koronavirüs salgını ile mücadele sürerken, o ülkeden korkutan bir açıklama geldi. Gizemli hastalık olarak ortaya çıktıktan sonra küresel bir salgın haline gelen koronavirüs salgını bitmeden bir salgın alarmı daha verildi.
Tüm dünya koronavirüs salgını ile mücadele ederken Tanzanya'da korkutan gizemli hastalık baş gösterdi. Bugüne kadar 15 kişinin hayatını kaybettiği gizemli hastalığa yakalananlarda baş dönmesi, mide bulantısı ve kan kusması görüldü.

KAN KUSMASINA YOL AÇIYOR
Tanzanya'da henüz teşhis edilemeyen hastalık nedeniyle 15 kişi hayatını kaybetti, 50'den fazla kişi de hastaneye kaldırıldı. Ülkenin batısındaki Mbeya şehrinde, yakalananlarda baş dönmesi, mide bulantısı ve kan kusmasına yol açan bir hastalık ortaya çıktı.

Chunya Kamu Sağlığı İdaresi Başkanı Felista Kisandu basına yaptığı açıklamada, onlarca kişinin hastaneye kaldırıldığını ve hepsinin benzer şikayetleri olduğunu söyledi.

NEDENİ TESPİT EDİLEMEDİ
Hastalığın nedeninin henüz tespit edilemediğini dile getiren Kisandu, ön araştırmaların hastaların çoğunun daha önce mide ülseri ya da karaciğer hastalığı yaşamış erkeklerden oluştuğunu gösterdiğini belirtti.

Tanzanya Sağlık Bakanı Doroth Gwajima, durumu incelemesi için bölgeye uzman bir ekibin gönderildiğini açıkladı. Mbeya bölgesinde 2018'de de benzer şikayetlerle birçok kişinin hastaneye yatırıldığı öğrenildi.
 GÜNÜN MANŞETLERİ İÇİN TIKLAYIN
GÜNÜN MANŞETLERİ İÇİN TIKLAYIN









